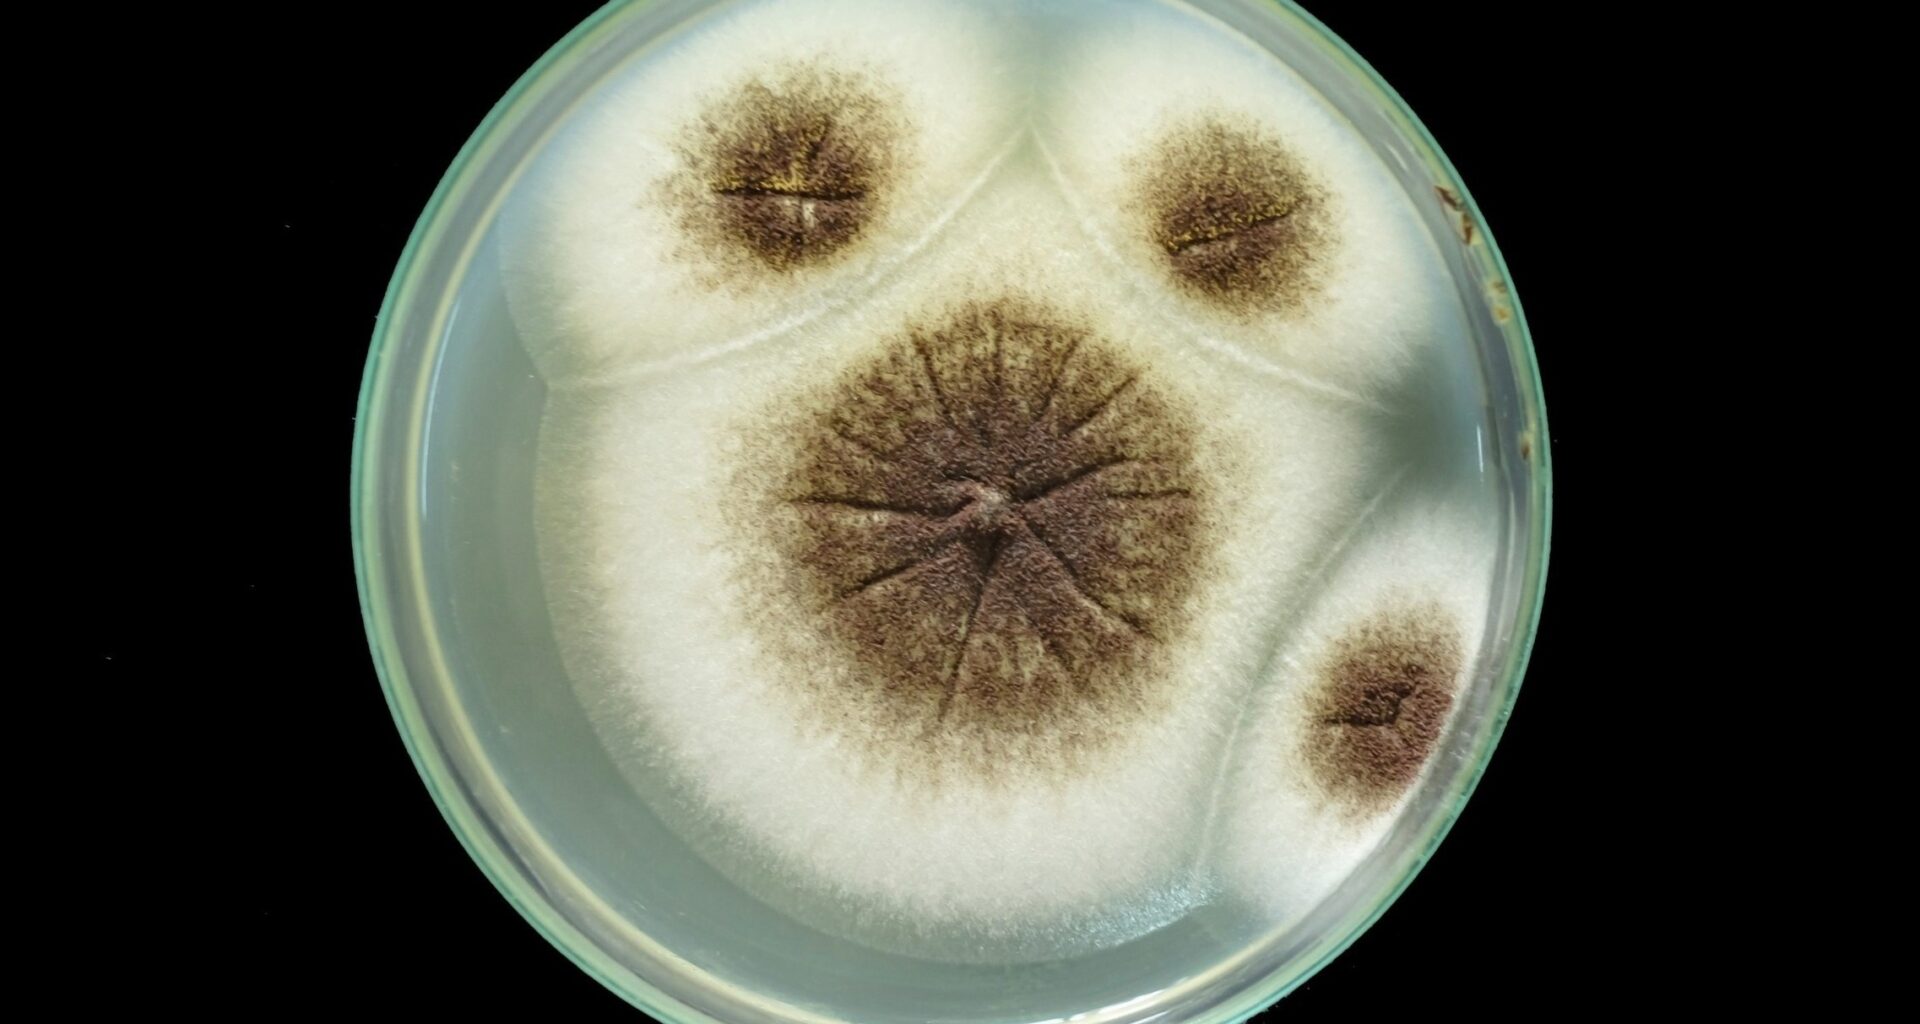
Mars missions face new contamination risk from hardy fungus

Keeping Mars free from Earth life is one of the most important rules in space exploration. If microbes from our planet were to survive the journey, they could interfere with experiments or even mimic signs of alien life.
Now, scientists have found evidence that one resilient fungus may be able to do just that.
Discovered in spacecraft cleanrooms, the fungus survived multiple stressors designed to simulate Mars, highlighting a potential gap in how missions protect other worlds from contamination.
Survivor in cleanrooms
Inside spacecraft assembly cleanrooms, researchers found fungal strains that had already endured the cleaning meant to remove Earth microbes from Mars-bound hardware.
Dr. Kasthuri Venkateswaran documented Aspergillus calidoustus as the strain that kept making it through the harshest stages.
At NASA’s Jet Propulsion Laboratory (JPL), Venkateswaran’s team followed the fungus from cleaning heat through space radiation to Martian stress.
That boundary turns the finding into a risk problem for mission planners, not a claim that Mars is already threatened.
Built for extreme survival
Among 27 fungal strains from Mars 2020 rover assembly areas, 23 survived an early blast of germ-killing light before deeper testing.
Under that light, those spores showed unusual tolerance to ultraviolet radiation – high-energy sunlight that can damage cells on exposed surfaces.
Those conidia, dry reproductive spores that help fungi spread, allowed the fungus to stay inactive through heat, cold, and radiation for long periods.
“Microorganisms can possess extraordinary resilience to environmental stresses,” said Venkateswaran.
Mars makes fungus survival harder
Mars is a harsh place to survive. Its thin carbon dioxide atmosphere does little to block intense sunlight, leaving the dry surface exposed to damaging radiation during the day.
Even so, in lab tests, Aspergillus calidoustus managed to survive 24 hours of simulated Martian sunlight on spacecraft-grade metal – though its numbers dropped sharply, by about 1,000-fold.
Adding a layer of regolith – the loose rock and dust that covers Mars – sometimes reduced the damage, but not in any consistent way. It offered some shielding, but not enough to reliably protect the spores.
What finally stopped the fungus was not a single condition but several hitting at once – a critical point, because on Mars, stresses rarely act alone.
Cold makes the difference
Temperature turned out to be a key part of the story. When samples were cooled to -76°F and exposed to radiation at the same time, the outcome shifted.
Under those combined conditions – cold air and harsh sunlight – the fungus could no longer grow. Its cell surfaces became damaged and scarred, leaving far fewer surviving spores behind.
But cold by itself was not enough to wipe it out. When sunlight was removed from the equation, some spores still held on.
That pattern points to a bigger takeaway. Survival depended on combinations of stress, not just one factor, suggesting that standard cleaning tests may miss how space conditions actually stack up during a real mission.
Radiation leaves lasting damage
During spaceflight testing, the conidia faced ionizing radiation, particle energy strong enough to break chemical bonds over long periods.
After one month, living spores fell by 35 percent, and after six months they fell by 57 percent compared with unexposed samples.
Months of low-level radiation look different from one harsh blast, because damage accumulates slowly over time.
Such endurance matters for Mars missions, where a hidden survivor would spend months inside hardware before landing on another world.
Heat leaves survivors
Before launch, some spacecraft parts undergo dry-heat microbial reduction, baking hardware to cut living contamination without chemicals.
At 257°F, Aspergillus calidoustus outlasted another fungus and matched a tough bacterial spore during early heat exposure.
Raising the heat to 302°F killed all three tested organisms after only five minutes in the same setup.
By surviving lower heat, the fungus challenged cleaning habits that measure success mainly against bacterial spores on mission hardware.
Expanding contamination safeguards
For NASA, planetary protection, rules that limit biological contamination between worlds, protects exploration from false clues while preserving the science.
Standard screens still lean heavily on bacterial spores, so fungal bioburden, the living microbes on equipment, may slip through between checks.
“This does not mean contamination of Mars is likely, but it helps us better quantify potential microbial survival risks,” said Venkateswaran.
Engineers call that forward contamination, Earth microbes carried to another world like Mars, and this fungus narrows the margin for error.
Fungi pose wider threats
Beyond spaceflight, hardy fungal spores can trouble industries that rely on heat, radiation, or spotless rooms far beyond launch pads.
Outside spacecraft, the Centers for Disease Control and Prevention (CDC), lists this fungal group as a lung infection risk for people with weakened immunity.
Food and drug makers also fight fungal survival, because spores can persist when ordinary cleaning looks successful across production lines.
Clearer fungal testing could improve spacecraft safety while giving other sterile industries better warning signs before a costly failure.
Survival doesn’t mean success
Even with these findings, important limits remain. No experiment showed that this fungus could actually grow, spread, or reproduce on Mars under the same conditions.
Survival, in this case, only means that some spores stayed alive after harsh treatment. It does not mean Mars would become habitable or welcoming to Earth life.
Real Martian conditions could be far more complex. Salts, shifting dust, long periods of darkness, and chemical stresses may interact in ways the lab tests did not fully capture.
That gap points to what comes next. Future experiments need to follow fungi across full mission timelines, tracking what happens not just after cleaning or landing, but throughout the journey.
For spacecraft teams, the takeaway is clear. Cleaning protocols now have a sharper target – fungi that can survive individual stresses but may fail when multiple hazards combine.
That insight could help refine heat treatments, expand monitoring, and better protect the search for life on Mars before missions ever leave Earth.
The study is published in the journal Applied and Environmental Microbiology.
—–
Like what you read? Subscribe to our newsletter for engaging articles, exclusive content, and the latest updates.
Check us out on EarthSnap, a free app brought to you by Eric Ralls and Earth.com.
—–